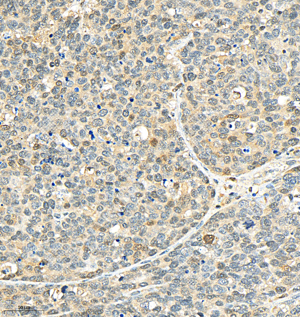
Immunohistochemistry analysis of P38. Sample: Human gastric carcinoma, 4% PFA 12-24h. Antigen retrieval: Citrate buffer, pressure cooker 2min. Primary antibody: 1:500, 4C overnight. Secondary antibody: HRP conjugated Goat Anti-Rabbit lgG, 1:200, RT, 1h.

Anti-Recombinant-p38 antibody [SR0675] (STJA0010675)
SPECIFICATIONS
ClonalityMonoclonal
HostRabbit
ConjugationUnconjugated
IsotypeIgG
ImmunogenKLH conjugated Synthetic peptide corresponding to Human p38
General Information
| Short Description | Rabbit monoclonal anti-Recombinant-p38 for use in WB, IHC and IF in Human, Mouse and Rat samples. Datasheet included with dilution recommendations, and related reagents. |
| Applications | WB/IHC/IF |
| Host | Rabbit |
| Reactivity | Human/Mouse/Rat |
| Note | STRICTLY FOR FURTHER SCIENTIFIC RESEARCH USE ONLY (RUO). MUST NOT TO BE USED IN DIAGNOSTIC OR THERAPEUTIC APPLICATIONS. |
Product Properties
| Clonality | Monoclonal |
| Clone ID | SR0675 |
| Isotype | IgG |
| Conjugation | Unconjugated |
| Purification | Affinity purification |
| Dilution Range | WB (H, M, R) 1:1000-1:2000IHC/IF (H, M, R) 1:500-1:1000 |
| Formulation | PBS with 0.15% ProClin300, 100 Mu g/mL BSA and 50% glycerol. |
| Storage Instruction | Store at-20C for up to one year, and avoid repeated freeze-thaw cycles. |
Target Information
| Gene Symbol | MAPK14 |
| Gene ID | 1432 |
| Uniprot ID | MK14_HUMAN |
| Immunogen | KLH conjugated Synthetic peptide corresponding to Human p38 |
Additional Info
| Post Translational Modifications | Dually phosphorylated on Thr-180 and Tyr-182 by the MAP2Ks MAP2K3/MKK3, MAP2K4/MKK4 and MAP2K6/MKK6 in response to inflammatory citokines, environmental stress or growth factors, which activates the enzyme. Dual phosphorylation can also be mediated by TAB1-mediated autophosphorylation. TCR engagement in T-cells also leads to Tyr-323 phosphorylation by ZAP70. Dephosphorylated and inactivated by DUPS1, DUSP10 and DUSP16. PPM1D also mediates dephosphorylation and inactivation of MAPK14. Acetylated at Lys-53 and Lys-152 by KAT2B and EP300. Acetylation at Lys-53 increases the affinity for ATP and enhances kinase activity. Lys-53 and Lys-152 are deacetylated by HDAC3. Ubiquitinated. Ubiquitination leads to degradation by the proteasome pathway. |
| Function | Serine/threonine kinase which acts as an essential component of the MAP kinase signal transduction pathway. MAPK14 is one of the four p38 MAPKs which play an important role in the cascades of cellular responses evoked by extracellular stimuli such as pro-inflammatory cytokines or physical stress leading to direct activation of transcription factors. Accordingly, p38 MAPKs phosphorylate a broad range of proteins and it has been estimated that they may have approximately 200 to 300 substrates each. Some of the targets are downstream kinases which are activated through phosphorylation and further phosphorylate additional targets. RPS6KA5/MSK1 and RPS6KA4/MSK2 can directly phosphorylate and activate transcription factors such as CREB1, ATF1, the NF-kappa-B isoform RELA/NFKB3, STAT1 and STAT3, but can also phosphorylate histone H3 and the nucleosomal protein HMGN1. RPS6KA5/MSK1 and RPS6KA4/MSK2 play important roles in the rapid induction of immediate-early genes in response to stress or mitogenic stimuli, either by inducing chromatin remodeling or by recruiting the transcription machinery. On the other hand, two other kinase targets, MAPKAPK2/MK2 and MAPKAPK3/MK3, participate in the control of gene expression mostly at the post-transcriptional level, by phosphorylating ZFP36 (tristetraprolin) and ELAVL1, and by regulating EEF2K, which is important for the elongation of mRNA during translation. MKNK1/MNK1 and MKNK2/MNK2, two other kinases activated by p38 MAPKs, regulate protein synthesis by phosphorylating the initiation factor EIF4E2. MAPK14 also interacts with casein kinase II, leading to its activation through autophosphorylation and further phosphorylation of TP53/p53. In the cytoplasm, the p38 MAPK pathway is an important regulator of protein turnover. For example, CFLAR is an inhibitor of TNF-induced apoptosis whose proteasome-mediated degradation is regulated by p38 MAPK phosphorylation. In a similar way, MAPK14 phosphorylates the ubiquitin ligase SIAH2, regulating its activity towards EGLN3. MAPK14 may also inhibit the lysosomal degradation pathway of autophagy by interfering with the intracellular trafficking of the transmembrane protein ATG9. Another function of MAPK14 is to regulate the endocytosis of membrane receptors by different mechanisms that impinge on the small GTPase RAB5A. In addition, clathrin-mediated EGFR internalization induced by inflammatory cytokines and UV irradiation depends on MAPK14-mediated phosphorylation of EGFR itself as well as of RAB5A effectors. Ectodomain shedding of transmembrane proteins is regulated by p38 MAPKs as well. In response to inflammatory stimuli, p38 MAPKs phosphorylate the membrane-associated metalloprotease ADAM17. Such phosphorylation is required for ADAM17-mediated ectodomain shedding of TGF-alpha family ligands, which results in the activation of EGFR signaling and cell proliferation. Another p38 MAPK substrate is FGFR1. FGFR1 can be translocated from the extracellular space into the cytosol and nucleus of target cells, and regulates processes such as rRNA synthesis and cell growth. FGFR1 translocation requires p38 MAPK activation. In the nucleus, many transcription factors are phosphorylated and activated by p38 MAPKs in response to different stimuli. Classical examples include ATF1, ATF2, ATF6, ELK1, PTPRH, DDIT3, TP53/p53 and MEF2C and MEF2A. The p38 MAPKs are emerging as important modulators of gene expression by regulating chromatin modifiers and remodelers. The promoters of several genes involved in the inflammatory response, such as IL6, IL8 and IL12B, display a p38 MAPK-dependent enrichment of histone H3 phosphorylation on 'Ser-10' (H3S10ph) in LPS-stimulated myeloid cells. This phosphorylation enhances the accessibility of the cryptic NF-kappa-B-binding sites marking promoters for increased NF-kappa-B recruitment. Phosphorylates CDC25B and CDC25C which is required for binding to 14-3-3 proteins and leads to initiation of a G2 delay after ultraviolet radiation. Phosphorylates TIAR following DNA damage, releasing TIAR from GADD45A mRNA and preventing mRNA degradation. The p38 MAPKs may also have kinase-independent roles, which are thought to be due to the binding to targets in the absence of phosphorylation. Protein O-Glc-N-acylation catalyzed by the OGT is regulated by MAPK14, and, although OGT does not seem to be phosphorylated by MAPK14, their interaction increases upon MAPK14 activation induced by glucose deprivation. This interaction may regulate OGT activity by recruiting it to specific targets such as neurofilament H, stimulating its O-Glc-N-acylation. Required in mid-fetal development for the growth of embryo-derived blood vessels in the labyrinth layer of the placenta. Also plays an essential role in developmental and stress-induced erythropoiesis, through regulation of EPO gene expression. Isoform MXI2 activation is stimulated by mitogens and oxidative stress and only poorly phosphorylates ELK1 and ATF2. Isoform EXIP may play a role in the early onset of apoptosis. Phosphorylates S100A9 at 'Thr-113'. Phosphorylates NLRP1 downstream of MAP3K20/ZAK in response to UV-B irradiation and ribosome collisions, promoting activation of the NLRP1 inflammasome and pyroptosis. (Microbial infection) Activated by phosphorylation by M.tuberculosis EsxA in T-cells leading to inhibition of IFN-gamma production.phosphorylation is apparent within 15 minutes and is inhibited by kinase-specific inhibitors SB203580 and siRNA. |
| Protein Name | Mitogen-Activated Protein Kinase 14Map Kinase 14Mapk 14Cytokine Suppressive Anti-Inflammatory Drug-Binding ProteinCsaid-Binding ProteinCsbpMap Kinase Mxi2Max-Interacting Protein 2Mitogen-Activated Protein Kinase P38 AlphaMap Kinase P38 AlphaStress-Activated Protein Kinase 2aSapk2a |
| Database Links | Reactome: R-HSA-168638Reactome: R-HSA-171007Reactome: R-HSA-198753Reactome: R-HSA-2151209Reactome: R-HSA-2559580Reactome: R-HSA-418592Reactome: R-HSA-432142Reactome: R-HSA-4420097Reactome: R-HSA-450302Reactome: R-HSA-450341Reactome: R-HSA-450604Reactome: R-HSA-525793Reactome: R-HSA-5668599Reactome: R-HSA-6798695Reactome: R-HSA-6804756Reactome: R-HSA-9662834Reactome: R-HSA-9824585 |
| Cellular Localisation | CytoplasmNucleus |
| Alternative Antibody Names | Anti-Mitogen-Activated Protein Kinase 14 antibodyAnti-Map Kinase 14 antibodyAnti-Mapk 14 antibodyAnti-Cytokine Suppressive Anti-Inflammatory Drug-Binding Protein antibodyAnti-Csaid-Binding Protein antibodyAnti-Csbp antibodyAnti-Map Kinase Mxi2 antibodyAnti-Max-Interacting Protein 2 antibodyAnti-Mitogen-Activated Protein Kinase P38 Alpha antibodyAnti-Map Kinase P38 Alpha antibodyAnti-Stress-Activated Protein Kinase 2a antibodyAnti-Sapk2a antibodyAnti-MAPK14 antibodyAnti-CSBP antibodyAnti-CSBP1 antibodyAnti-CSBP2 antibodyAnti-CSPB1 antibodyAnti-MXI2 antibodyAnti-SAPK2A antibody |
Information sourced from Uniprot.org